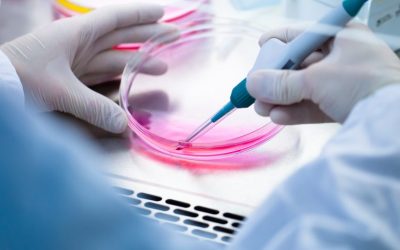
La restauración de la expresión de frataxina podría detener la progresión de la FA

Noticias
¿Por qué sólo ciertas células del cerebro se dañan en la Ataxia de Friedreich?
Estudio puede explicar por qué sólo ciertas células del cerebro se dañan en la Ataxia de Friedreich Fuente, 16 de marzo de 2017 La degeneración selectiva de ciertas neuronas en pacientes con ataxia de Friedreich se puede explicar por el efecto que tiene la falta de...
La tolerancia al ejercicio y la capacidad física de los pacientes con ataxia de Friedreich tardía
La tolerancia al ejercicio y la capacidad física de los pacientes con ataxia de Friedreich tardía Fuente, 12 de marzo de 2017 Mederic Descoins, Chantal Verkindt, Bruno Lemarchand, Dalleau Georges, Nicolas Perrot, Claude Mignard, Ariane Choumert Neurológica Journal,...
El papel de los astrocitos en los déficits cerebelares en la deficiencia de frataxina
El papel de los astrocitos en los déficits cerebelares en la deficiencia de frataxina: La protección por el factor de crecimiento similar a la insulina I Fuente, 7 de marzo de 2017 Destacado • Los astrocitos cerebelosos muestran mayor vulnerabilidad a la...
¿Qué es la Ataxia? Cadena SER
¿Qué es la Ataxia? Cadena SER Isabel Campos, presidenta de la Asociación de Ataxias de Ciudad Real con Mónica Patón, conductora del espacio SER Capaces / SER Ciudad Real Con la presidenta de la Asociación de Ataxias de Ciudad Real conocemos en qué consiste y qué...
Ataxia telangiectasia: Novedades en la lucha por la investigación
Novedades en la lucha por la investigación de la ataxia telangiectasia Comienza esta semana un ensayo clínico a nivel mundial en el Hospital La Paz en el que entrarán alrededor de 7 niños españoles Aefat, la asociación que agrupa a las familias afectadas por esta...
Tras la pista de nuevos tratamientos para la ataxia de Friedreich
Tras la pista de nuevos tratamientos para la ataxia de Friedreich Muchos de quienes padecen la enfermedad van empeorando hasta que se ven abocados a utilizar una silla de ruedas. Fuente, 4 de marzo de 2017 Un trabajo demuestra que el factor neurotrófico derivado del...
La restauración de la expresión de frataxina podría detener la progresión de la FA
La restauración de la expresión de frataxina podría detener la progresión de la FA, mejorando los síntomas Fuente, 14 de febrero de 2017. Un estudio publicado en la revista científica 'Human Molecular Genetics' sugiere que el tratamiento de células nerviosas...
Acto oficial del Día mundial de las ER en el Museo Del Prado
Acto oficial del Día mundial de las ER en el museo Del Prado con la presencia de SM la Reina, la ministra de sanidad, multitud de autoridades y en representación de FEDAES Eneraldo Romano e Isabel Campos Fuente SM la Reina subraya la importancia de la investigación...
Boletín Nº 155
Boletín Nº 155 Cada mes desde el 2001, año de la fundación de nuestra federación, nos acercamos a vosotros con un boletín recopilatorio mensual que ofrece las noticias más destacadas sobre Ataxia y sobre las actividades que desarrolla la Federación de Ataxias de...
Editorial 155. Ataduras físicas y económicas.
Editorial 155. Ataduras físicas y económicas. Ataduras físicas y económicas. Una vez más las circunstancias nos obligan a tratar en este apartado el tema de la “Ley 39/2006, de 14 de diciembre, de Promoción de la Autonomía Personal y Atención a las personas en...
Ataxias en “Gente COCEMFE”
Ataxias en “Gente COCEMFE” Fuente, 28 de febrero de 2017 La protagonista del nuevo episodio de “Gente COCEMFE” es Cristina Jiménez, con ataxia de Friedreich, una enfermedad caracterizada por dificultades de coordinación y de movilidad, así como para tragar y hablar,...
Negociación de precios en los medicamentos para enfermedades raras
Negociación de precios en los medicamentos para enfermedades raras Fuente: Séverine Henrard a & Francis Arickx b a) Instituto de Salud y Sociedad (IRSS), Universidad Catolica de Lovaina, Clos Chapelle-aux-Champs, 30 B1.30.15, 1200 Bruselas, Bélgica. b) ...
Referencias científicas Nº 155
Referencias científicas Nº 155 https://link.springer.com/article/10.1007%2Fs12311-017-0848-7 Measuring Inhibition and Cognitive Flexibility in Friedreich Ataxia Authors Authors and affiliations Louise A. Corben Felicity Klopper Monique Stagnitti...
Chondrial Therapeutics autoriza una terapia para la Ataxia de Friedrech
Chondrial Therapeutics autoriza una terapia para la Ataxia de Friedrech Fuente, 16 de febrero de 2017 Chondrial Therapeutics ha autorizado el compuesto en investigación CTI-1601 para el tratamiento de la ataxia de Friedreich (FA) desde la Corporación de la...
Las Noticias que aquí mencionamos son estrictamente informativas.
No proporciona asesoramiento médico, diagnóstico o tratamiento.
Este contenido no pretende ser un sustituto del consejo, diagnóstico o tratamiento médico profesional.
Siempre busque el consejo de su médico u otro proveedor de salud cualificado con cualquier pregunta que pueda tener con respecto a una condición médica. Nunca ignore el asesoramiento médico profesional ni se demore en buscarlo por algo que haya leído en este sitio web.
Suscríbete al boletín de Noticias
Recibe las noticias más significativas sobre Ataxia